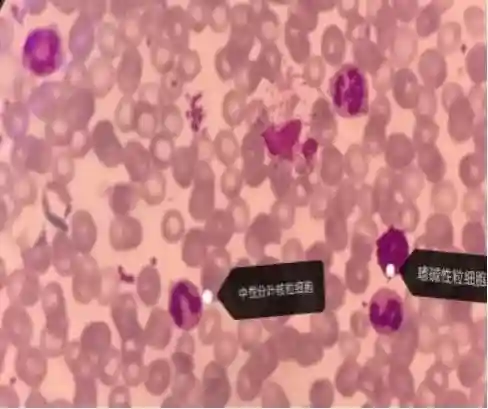
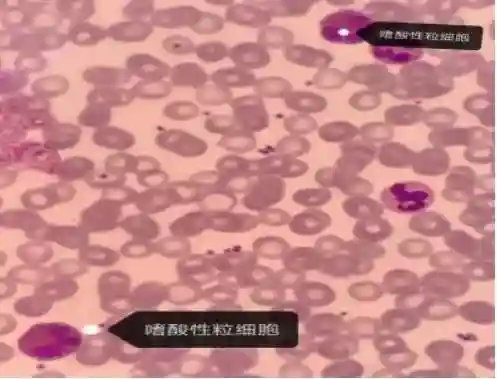

前言
儿童白细胞增高并不少见,原因多样,但通过血常规结果和血涂片分析,为临床医生提供线索,及时找出白细胞持续升高的原因。

案例经过
5岁男孩,因发现白细胞增多两月余入院,患儿两月前无明显诱因全身皮肤出现散在条索状丘疹,压之不褪色,伴瘙痒,起病后在多家医院就诊查血常规WBC增多,NEUT为主,HGB、PLT基本正常,经抗感染治疗,白细胞计数无好转。
于8月18日到我院进一步检查治疗,体格检查,体温36.2℃脉搏90次/分,呼吸20次/分,血压90/40mmHg,体重18.0Kg,神志清,精神反应好,全身皮肤未见皮疹,无出血点,颈部可触及数个直径约1.0cm淋巴结,质软,活动好,口腔黏膜光滑,咽充血,扁桃体I°肿大,胸骨无明显压痛,双肺呼吸音清,未闻及干湿罗音,心音有力,律齐,各瓣膜听诊区未闻及杂音。腹平软,未及包块,肝、脾肋下未触及。
实验室检查:表1外院血常规


图18月18日入院血常规

图2儿童生化全套
血涂片特点:外周血白细胞数增多,晚幼粒细胞及嗜碱性分叶粒细胞多见。淋巴细胞比例减低,红细胞形态未见异常。未见血液寄生虫。不排除慢性髓系白血病,建议做骨髓细胞学检测。
图3100X(瑞氏染色)外周血涂片
图41000X(瑞氏染色)外周血涂片

图51000X(瑞氏染色)外周血涂片
骨髓细胞形态结果:提示骨髓增殖性疾病(慢性髓系白血病不除外),建议做染色体及BCR-ABL1融合基因检测。

图61000X(瑞氏染色)骨髓涂片

图71000X(瑞氏染色)骨髓涂片

图81000X(瑞氏染色)骨髓涂片

图9骨髓细胞学报告单


图10染色体报告
图11融合基因检测报告
疾病介绍
慢性髓系白血病(CML)诊断标准:凡有不明原因的持续性白细胞数增高,根据典型的血象、骨髓象改变,脾大,Ph染色体阳性或BCR-ABL融合基因阳性即可做出诊断。[1]综观以上检查结果,结合诊断标准,该患儿临床诊断CML明确。
CML是一种发生在多能造血干细胞的恶性骨髓增殖性肿瘤,主要涉及髓系。患者外周血粒细胞显著增多,在受累的细胞系中,可找到Ph染色体和(或)BCR-ABL融合基因。CML在我国年发病率为(0.39~0.99)/10万。各年龄组均可发病,多见于中年人,男多于女,起病慢,早期无自觉症状,分为慢性期(CP)、加速期(AP)和急变期(BP)。[1]
一般症状:CML症状缺乏特异性,常见乏力、易疲劳、低热、腹部不适。[2]
肝脾大:脾大见于90%的CML患者。脾大程度与病情、病程、特别是WBC数密切相关。肝大见于40%~50%患者。[2]
加速期(AP)/急变期(BP)出现不明原因的发热、虚弱、骨痛、脾脏进行性肿大、其他髓外器官浸润表现、贫血加重或出血,以及对原来有效的药物失效,则提示进入加速期或急变期。急变期为CML终末期,多数呈急髓变,其次是急淋变。[2]
案例分析
本案例患儿白细胞数持续升高两个多月,最高可达39.8×109/L,且外周血晚幼粒细胞及嗜碱粒细胞多见,符合CML外周血特点。患儿虽无CML常见症状(肝脾大),但临床医生根据外周血涂片的建议进行骨髓细胞学、染色体和融合基因检查。
骨髓增生极度活跃,细胞分类与外周血相似,可见到各期粒细胞,其中以中、晚幼粒细胞为主,嗜酸和嗜碱性粒细胞多见,红细胞系相对减少,粒:红约14.08。中性粒细胞碱性磷酸酶阳性率和积分减低,Ph染色体和BCR-ABL融合基因阳性,最终确诊为CML。
讨论
CML是常见恶性血液病肿瘤之一,由骨髓干细胞增殖性克隆所致。据美国报道,儿童CML占15岁以下儿童患白血病的2%。[3-4]与成人CML表现不同的是,儿童CML白细胞计数升高,巨脾比例较高[5]。
本案例血常规显示患儿白细胞数升高,体格检查未见肝脾肿大,与类白血病反应外周血白细胞显著增高[6]表现一致。该患儿嗜碱性粒细胞的绝对数是增多的,因而可初步将两者区分开。[7]临床上对其进行Ph染色体和BCR-ACL融合基因相关的实验室检查,结果显示为阳性,该患儿确诊为CML。
以上病例,从病历上可知6月11日白细胞开始持续升高(没有提供白细胞分类数据),8月18日检查血常规显示白细胞总数,嗜碱粒细胞比例和未成熟粒细胞比例增高,结合血涂片提示CML可能。对于检验工作者,准确的提示可以帮助临床医生有目的地选择检查项目;对于临床医生,诊断明确可以更快地为患者提供相应的治疗;对于患者,及时找出病因接受甲磺酸伊马替尼治疗,目前情况良好。
参考文献
[1]葛均波,徐永健.内科学八年制第三版[M].北京:人民卫生出版社,2015:838.
[2]葛均波,徐永健.内科学第9版[M].北京:人民卫生出版社,2019:577-578.
[3]FedericoR,FilippoM,,present,andfutureofBcr-Ablinhibitors:fromchemicaldevelopmenttoclinicalefficacy[J].JHematolOncol,2018,11(1):84
[4]ChenY,WangH,KantarjianH,etal.TrsinchmnicmyeloidleukemiaincidenceandsurvivalintheUnitedSlatesfrom1975to2009.LeukLymphoma,2013,54:141l-1417.
[5]HijiyaN,MillotF,:clinicalfindings,management,andunansweredquestions[J].PediatrClinNorthAm,2015,62(1):107-119.
[6]陈灏珠.实用内科学[M].第13版.北京:人民卫生出版社,2009:2525-2527.
[7]陈莹.慢性粒细胞白血病与类白血病的临床病理学分析[J].医药前沿,2018,8(10):46-47.



.jpeg)

